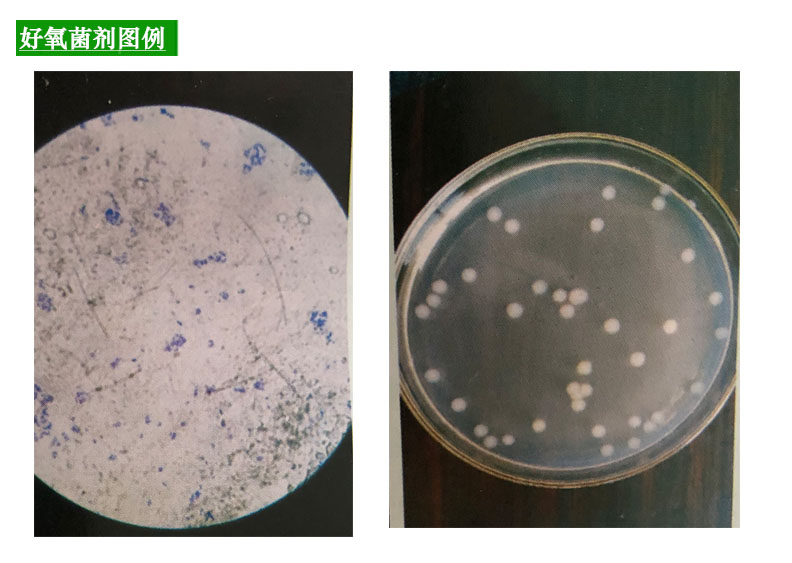

| 颜色分类 | 售价 | 原价 | 库存 | 重量 | 体积 | 编码 | 条码 | 购买数量 | 操作 |
|---|---|---|---|---|---|---|---|---|---|
|
|
¥ 登录可见 | ¥ 登录可见 | 9999 件 | 619546765137 |
|
||||
|
|
¥ 登录可见 | ¥ 登录可见 | 9999 件 | 619546765137 |
|
没有相关规格
看了又看